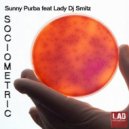

- DJ record pool
- Artist list
- Sunny Purba
- All tracks
Sunny Purba — all tracks
- GO TO PAGE
- 31.07.17

LABELLAD Publishing & Records
PREMIUM FLAC 0
0
0
Epitome 1979 (Original Mix)
Sunny Purba ft. DJ Smitz
5:00
- 16.04.13

6:00
- 19.11.12

LABELLAD Publishing & Records
PREMIUM FLAC 0
0
0
Megalomaniac (Original Mix)
Sunny Purba ft. DJ Miss Smitz
6:20
- 24.10.12

LABELLAD Publishing & Records
PREMIUM FLAC 0
0
0
"Ahmedabad Dry Run" & Rain! (Original Mix)
Sunny Purba feat Lady DJ SMITZ
5:54
- 05.07.12

LABELLAD Publishing & Records
PREMIUM FLAC 0
0
1
Lithium 6 (Original Mix)
Sunny Purba ft. DJ Miss Smitz
6:15
- 04.06.12

6:45
- 29.02.12
LABELLAD Publishing & Records
PREMIUM FLAC 0
0
0
SOCIOMETRIC (Original Mix)
Sunny Purba feat Lady DJ SMITZ
7:08